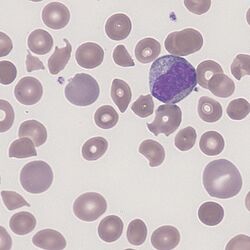

Polychromatic Red Cells
From haematologyetc.co.uk
Derivation: ‘’Polychromatic - of two or varying colours’’
Appearance
Erythrocytes with an additional blue-tone in their cytoplasm; the blue may be barely visible or may be marked. Polychromatic erythrocytes are generally larger than normal erythrocytes.
Images: The key feature is the blue tinge to the cell caused by residual protein-synthesising elements (ribosomes and mRNA). The precise appearance is dependent on blood film staining and may be more or less obvious with different staining conditions, so comparison with normal mature red cells is essential. Here the colour of the polychromatic cell (arrowed) is clearly distinct from the other cells. Note also a size difference – newly formed red cells also have more membrane and intracellular organelles so generally appear larger than the mature forms.
Significance
There will be a cause, but the seriousness depends on context: Numbers are increased physiologically where there is premature erythrocyte destruction e.g. haemolysis or bleeding. However, these cells will also be present when bone marrow has been infiltrated (generally other precursor cells of all types also appear in the circulation - a "leukoerythroblastic" picture).
When marked ploychromasia is noted, a search for associated disease should be made. Remember also that reduced polychromatic cells in the presence of anaemia may suggest an insufficient reticulocyte response, indicating marrow suppression (e.g. Parvovirus B19 infection).
Pitfalls
The diffuse blue colour of polychromatic cells is generally easy to detect and can readily be distinguished from basophilic stippling, but may vary with staining conditions. Remember that some polychromatic cells will always circulate, if in doubt as to the number of cells a reticulocyte count (manually or by analyser) will produce a more accurate measurement.
Causes
| PHYSIOLOGICAL RESPONSE (acute) |
|---|
| 1. Acute response to current blood cell loss: e.g. bleeding or haemolysis |
| 2. Recovery from haematinic deficiency e.g. iron replacement or B12 folate replacement |
| PHYSIOLOGICAL RESPONSE (chronic) |
| 1. Increased production to compensate for shortened erythrocyte lifespan e.g. haemoglobinopathy or inherited membrane disorder |
| PATHOLOGICAL CAUSES |
| 1. Bone marrow infiltration - usually nucleated red cells and tear drop forms will be present and look also for primitive white cell precursors |
Clinical Examples
Clinical Image 1. Polychromatic cells in hereditary spherocytosis – here the polychromatic cells represent young cells released to compensate for the shortened lifespan of the spherocytic cells. The polychromatic cells can be distinguished from either spherocytes or normal cells by both their blue-tinge and their increased size. Clinical condition: hereditary spherocytosis
Clinical Image 2. In this case the polychromatic cells are released in response to a fragmentation anaemia. Note that the newly formed polychromatic cells are less likely to have been damaged and so appear rounder, but also that in this particular film their shade is more subtle because of staining conditions. Clinical condition: microangiopathic haemolysis
Pathobiology
Erythrocytes are not fully mature at the time they are released from bone marrow into blood – at this stage they contain mitochondria, ribosomes, and mRNA that support residual protein synthesis, and express receptor proteins on their membranes that support ongoing adhesion (in the spleen). The ribosomes and other elements are responsible for the blue cytoplasmic colouring, while the “excess” membrane and contents account for the relatively large size of the polychromatic cells. The final maturation and removal of these excess elements occurs in spleen. As a normal physiological process, some polychromatic cells will be found in the circulation of normal individuals, but increased numbers of polychromatic cells arise when cells leave the marrow early in response to physiological need or marrow infiltration. When stained with supravital dyes the remaining protein-synthetic elements (mRNA/ribosome) give the cells a “reticular” pattern, hence the name “reticulocyte”.